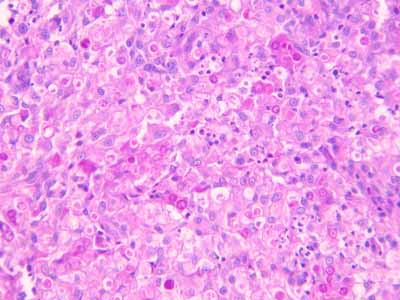

Auteurs :
Christian Collinot – Mai 2009
Clinique vétérinaire du ROC
117, avenue du maréchal LECLERC
86100 CHATELLERAULT
&
Éric Chauveau – Mai 2009
Clinique vétérinaire
306 avenue de la Liberté
86180 Buxerolles
Commémoratifs
Tigrette est une chatte de type européen tricolore, la partie noire étant tigrée de 5ans. Son poil est légèrement long de type semi-angora. Elle n’est pas stérilisée mais sous contraception orale. Elle vit à la campagne et se promène librement y compris en dehors du jardin.
Anamnèse
Elle présente une déformation du nez qui évolue depuis plusieurs mois.
Photo 1 : déformation du nez de face
Photo 2 : déformation sur le chanfrein de profil
Examen clinique
L’état général n’est pas affecté et la chatte n’a pas changé ses habitudes.
Examen dermatologique
Nous sommes en présence d’une lésion nodulaire du chanfrein, plus ou moins bicéphale, avec des lésions plus petites papulo-nodulaires qui descendent vers le planum nasal et atteignent même l’aile gauche de celui-ci.
Photo 3 : lésion nodulaire du chanfrein
qui est en partie alopécique et hyperpigmentée
Photo 4 : lésion en partie alopécique et hyperpigmentée
Deux zones ulcérées sont visibles, l’une au-dessus et l’autre en dessous
de la zone à proprement parlée nodulaire
Photo 5 : 2 zones ulcérées
Elles sont peut-être en partie dues à la mauvaise cicatrisation de 2 biopsies qui ont été effectuées 1,5 mois avant avec la plicature cicatricielle qui les borde (cf photo 6).
On note une zone hyperplasique, érythémateuse et alopécique sur le bout du nez ainsi que sur le bord des oreilles.
Photo 6 : zone érythémateuse du chanfrein et papulo-nodules atteignant l’aile de la narine
Photo 7 : zone érythémateuse du bord des oreilles
Diagnostic différentiel
- Abcès, granulome infectieux, stérile ou à corps étranger
- Mycoses profondes
- Lèpre féline et mycobactérioses atypiques
- Panniculite
- Néoplasme
Examens complémentaires
Compte tenu des différentiels, les biopsies sont retenues, il n’a pas été réalisé de ponction pour cytologie.
L’examen a été effectué par le laboratoire d’anatomie pathologique vétérinaire d’Amboise.
Ses conclusions sont : dermatite focale granulomateuse d’intensité marquée, avec éléments pathogènes intralésionnels. L’hypothèse d’une protothécose cutanée est mise en évidence, affection liée à Protothéca sp.
Photo 8 : histologie du nodule
Photo 9 : histologie du nodule vue rapprochée de la zone granulomateuse
Un test de dépistage pour le FIV et le FeLV est négatif pour les deux virus.
Diagnostic
Protothécose cutanée, pour la (les) lésions nodulaires du nez, les lésions érythémateuses alopéciques des zones mal couvertes à poils blancs étant probablement des lésions de dermatose solaire.
Traitement
La solution d’une exérèse chirurgicale large, très délabrante n’est pas retenue et un traitement de ketoconazole à la dose de 50mg (Tigrette pèse 3kg) est mis en place.
Suivi
Il est difficile de préciser si le traitement a limité l’extension de la maladie. Il n’a pas apporté de rémission, encore moins de guérison et après quelque temps, l’euthanasie de l’animal a été demandée.
Discussion
La protothècose est une infection classée par facilité dans les mycoses sous cutanées (pour sa forme cutanée). Prototheca sp est un organisme unicellulaire proche des algues du genre Chlorella, mais qui a perdu ses chloroplastes donc sa possibilité de fabriquer de la chlorophylle. Ce serait donc une « algose ». Elle a une répartition mondiale. C’est un organisme saprophyte qui se trouve dans les eaux usées, les déchets animaux et que l’on retrouve dans la sève d’arbre, sur les sols, dans les eaux stagnantes, elle contamine les systèmes hydriques voire les piscines. Sa contamination est décrite chez le chien, le chat, les bovins, les cervidés, les chiroptères et l’homme. C’est une maladie rare à très rare. Deux formes cliniques sont possibles, Prototheca wickerhamii est responsable de la forme cutanée et P. zopfii, de la forme systémique.
Dans la forme systémique, la contamination, après ingestion semble se faire au niveau du colon. Elle est décrite chez le chien mais pas chez le chat. La race Colley semble prédisposée, et la majorité des cas sont des femelles. La forme systémique touche rarement la peau. On retrouve des nodules sur différents organes (nœuds lymphatiques, poumons, yeux, cerveau, reins , foie, cœur) et des ulcérations du colon. Les symptômes sont liés aux sites d’attaque, diarrhée hémorragique, vomissements, cécité, troubles neurologiques, PUPD… Un amaigrissement avec atteinte de l’état général en découle.
Chez les bovins, on retrouve des entérites et des mammites.
Chez l’homme, trois formes sont décrites : cutanée, bursite de l’olécrane, forme disséminée.
Photo 10 : Prototheca zopfii
Dans la forme cutanée, il n’y a pas d’atteinte de l’état général. La contamination se fait par une blessure cutanée. On trouve des nodules (papules si plus petits), des croûtes et des ulcères voir des fistules. La lésion peut être unique ou multiple.
Chez le chien, les points de pression et les jonctions cutanéo-muqueuses (scrotum, niveau coussinets) sont particulièrement concernés.
Chez le chat, la forme cutanée est la seule décrite, on n’a pas décrit de prédisposition de race ou de sexe. Les atteintes préférentielles sont : les pattes, le nez, la tête, les pavillons auriculaires, la base de la queue.
Chez l’homme et le chien, un déficit de l’immunité à médiation cellulaire est souvent retrouvé, ce n’est pas le cas chez le chat.
Le diagnostic est anatomopathologique même si une aspiration à l’aiguille fine peut permettre à un cytologiste de retrouver les organismes en particulier sous forme de morulas comprenant des endospores dont les parois donnent un aspect de roue de voiture.
Photo 11 : culture Prototheca wickerhammii sur milieu Sabouraud (morulas)
Il faut prendre des précautions à cause du risque de contamination même si, pour l’homme, en l’absence de baisse des défenses immunitaires, le risque est faible.
Pour la forme cutanée qui nous intéresse, il faut essayer de biopsier ou mieux de retirer un nodule non ulcéré si cela est possible.
On décrit classiquement un épiderme acanthosique, qui peut être ulcéré. Le derme voire la zone sous dermique profonde est atteint. Le derme est le siège d’une réaction pyogranulomateuse mais plus souvent granulomateuse diffuse à nodulaire ou sont présents de nombreux organismes entiers ou dégradés dans et autour des macrophages. Le centre des lésions nodulaires peut être nécrotique.
Deux colorations particulières permettent de mieux repérer les Protothecas: la coloration à l’acide périodique de Schiff (PAS) et celle de Gomori methenamine silver.
On peut cultiver Prototheca à partir des punch de biopsies sur différents milieux (Sabouraud , gelose au sang).
Le traitement comprend si possible l’exérèse large du nodule si il est unique. L’amphotéricine B associée à la tétracycline a été utilisée chez l’homme. Les azolés, en particulier le fluconazole, même si le ketoconazole a déjà donné des résultats dans certains cas, sont conseillés. Le traitement est long (deux à six mois) et doit être continuer un mois après la guérison clinique. Les rechutes sont fréquentes à l’arrêt du traitement.
Pour en savoir plus
Les bibles : Muller et Kirk (small animal dermatology), Yager and co (dermatopathology and skin tumors), Lee Gross, Ihrke and co (skin diseases of dog and cats),
Bourdeau P.-Dermatomycoses non dermatophytiques des carnivores.-Encyclopédie vétérinaire, paris (Elsevier), 1996, Dermatologie 1000, 23p
VJ Stenner, B Mackay, T King, VRD Barrs, P Irwin, L Abraham, N Swift, N Langer, M Bernays, E Hampson, P Martin, MB Krockenberger, K Bosward, M Latter, R Malik Title: Protothecosis in 17 Australian dogs and a review of the canine literature : Medical Mycology, 2007, Vol 45, Iss 3, pp 249-266
Dechervois-I; Plassiart-G :Protothécose cutanéo-nasal chez un chien.PMCAC. 1998, 33: 2, 145-152.